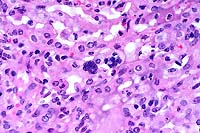

Results
AFIP Wednesday Slide Conference - No. 22
March 3, 1999
- Conference Moderator:
LTC Denzil Frost
Walter Reed Army Institute of Research
Division of Pathology
Washington, D.C. 20307-5100
-
- NOTE: Click on images for larger views. Use
browser's "Back" button to return to this page.
Return to WSC Case Menu
-
-
Case I - 98-0333 (AFIP 2663367)
- Signalment: Two to three-year-old, male, rhesus monkey
(Macaca mulatta).
-
- History: This animal had been infected intravenously
with chimeric simian/human immunodeficiency 89.6 (SHIV 89.6)
virus twelve weeks prior to euthanasia. He had severe weight
loss, diarrhea, and dyspnea at euthanasia. Prior to SHIV infection,
the monkey was seronegative for SIV, SRV, STLV, and Herpes B.
He also consistently tested negative for tuberculosis on intradermal
skin tests.
-
- Gross Pathology: The monkey was in poor nutritional
condition, with minimal subcutaneous and abdominal fat. The lungs
were multifocally reddened (congestion) and contained multifocal
to coalescing, red-brown, consolidated areas that completely
involved the apical lobe.
-
- Laboratory Results: Bordetella bronchiseptica was
isolated from the lungs at necropsy.
-
- Contributor's Diagnoses and Comments:
- 1. Lung: Pneumonia, interstitial and perivascular, subacute,
histiocytic, multifocal, moderate, with multinucleate syncytial
giant cells, rhesus monkey (Macaca mulatta), non-human primate.
2. Lung: Pneumonia, interstitial, fibrinosuppurative, subacute,
multifocal, moderate, with type II pneumocyte hyperplasia, karyomegaly
and intranuclear inclusion bodies.
3. Lung: Bronchopneumonia, fibrinonecrotic, suppurative, multifocal
to coalescing, moderate.
- Microscopic diagnoses in other organs not submitted included:
1. Spleen: Lymphoid depletion, diffuse, moderate, with scattered
periarteriolar lymphoid hyperplasia.
2. Thymus: Lymphoid depletion, diffuse, severe.
- 3. Lymph nodes, multiple: Follicular depletion and subinvolution,
multifocal-coalescing, moderate, with scattered follicular hyperplasia,
fibrosis, sinus histiocytosis, edema, subacute inflammation,
and erythrophagocytosis.
4. Small intestine, jejunum, ileum: Enteritis, subacute, diffuse,
mild, with crypt abscesses and Cryptosporidium organisms.
5. Colon: Colitis, subacute, multifocal, mild, with Cryptosporidium
organisms.
6. Bone marrow: Hyperplasia, myeloid, diffuse, moderate.
7. Tongue: Intraepithelial yeast and pseudohyphae, many, etiology
consistent with Candida sp.
8. Skeletal muscle, multiple: Sarcocysts, multifocal, moderate,
with perimysial hemorrhage.
-
- Simian immunodeficiency virus (SIV) infection of Asian macaques
has been used extensively to study the pathogenesis of AIDS in
human immunodeficiency virus type 1 (HIV-1)-infected humans.
The SIVmac model is limited, however, due to the divergence of
the envelope glycoproteins from HIV-1. Chimeric simian-human
immunodeficiency viruses (SHIV) containing the tat, rev, vpu,
and env genes of HIV-1 have been constructed and found to infect
a number of macaque species causing an AIDS-like illness. These
chimeric SHIV viruses will induce immune responses directed against
the HIV-1 envelope glycoproteins. This model is currently being
utilized for development of vaccine and therapy regimens for
HIV-1.
-
- The giant cell pneumonia seen in this case is typical of
SIVmac-induced giant cell pneumonia and is characterized by extensive
infiltration of alveolar septa and spaces by numerous macrophages
with abundant foamy cytoplasm and multinucleate giant cells of
macrophage-monocyte origin. The interstitial pneumonia with karyomegaly
and intranuclear inclusions is characteristic of cytomegalovirus,
a common secondary infection in SIVmac-infected animals. On transmission
electron microscopy, an unidentified cell in the lung was found
to contain an intranuclear inclusion body with peripheral clearing
of the nuclear chromatin. Dispersing the nuclear chromatin were
viral particles measuring 100 to 110 nm. The viral particle size
and morphology were consistent with those of the herpesviridae
group.
-
- The bronchopneumonia was thought to be due to secondary infection
with Bordetella bronchiseptica. Areas with intra-alveolar foamy
material suggestive of Pneumocystis carinii organisms were present
in some sections; however, special stains failed to confirm the
presence of these organisms. Findings in the lymphoid organs
and other tissues are typical of an advanced infection with pathogenic
SHIV and common secondary infections.
 4x
obj.
4x
obj.
- Case 22-1. Lung. Exudate fills an ulcerated bronchus
and extends into the surrounding parenchyma, obscuring normal
alveolar architecture.
 40x
obj.
40x
obj.
- Case 22-1. Lung. Alveoli are filled with neutrophils
and lined by type II pneumocytes which occasionally contain eosinophilic
intranuclear inclusions bodies.
 40x
obj.
40x
obj.
- Case 22-1. Lung. A syncytial giant cell is accompanied
by abundant foamy alveolar macrophages within and thickening
the septal walls (interstitial pneumonia).
 20x
obj
20x
obj 40x
obj
40x
obj
- Case 22-1.Lung. Immunohistochemistry demonstrates
positive cells (red) stained for Rhesus cytomegalovirus antigen
occuring multifocally within alveolar septa. Note scattered alveolar
multinucleated giant (syncytial) cells.
-
- AFIP Diagnoses:
- 1. Lung: Bronchopneumonia, necrotizing and suppurative, acute,
focally extensive, severe, with pleuritis, hemorrhage, and bacilli,
rhesus monkey (Macaca mulatta), nonhuman primate.
- 2. Lung: Pneumonia, interstitial, subacute, focally extensive,
moderate, with multinucleate giant cells and few eosinophilic
and basophilic intranuclear inclusions.
-
- Conference Note: Variably affecting the sections of
lung, there are multifocal to coalescing areas of atelectasis
and consolidation. Bronchioles are partially or completely filled
by numerous viable and degenerate neutrophils admixed with fewer
macrophages, necrotic respiratory epithelial cells, abundant
cellular debris, few bacilli, and mucin. There is occasional
segmental attenuation and loss of the bronchiolar epithelium.
Similar inflammatory cells partially or completely fill adjacent
alveoli.
-
- Additionally, there is multifocal thickening of alveolar
septa by neutrophils, macrophages, and type II pneumocytes. Pneumocytes
sometimes contain eosinophilic intranuclear inclusions that marginate
the chromatin, or large, basophilic inclusions that completely
fill the enlarged the nuclei. Alveoli sometimes contain large
multinucleate cells with abundant eosinophilic cytoplasm and
up to 15 peripheral nuclei. In addition, there are fewer multinucleate
cells with less cytoplasm and fewer, centrally located, nuclei.
The interstitial changes and multinucleate cells are most readily
observed at the interface of less affected lung parenchyma and
areas of consolidation.
-
- Several concurrent infectious agents complicate the histologic
lesions of the lung. The presence of bacilli in bronchioles and
bacterial culture results suggest that the bronchopneumonia was
primarily caused by infection with Bordetella bronchiseptica.
The interstitial pneumonia, with characteristic multinucleate
giant cells, was attributed to infection with SIVmac. Concurrent
infection with cytomegalovirus also contributed to the interstitial
pneumonia. These oppurtunistic pulmonary infections are common
in SIV/SHIV infected macaques.
-
- Contributor: Division of Pathology, Walter Reed Army
Institute of Research, Washington DC 20307-5100.
-
- References:
- 1. King NW: Simian immunodeficiency virus infections. In:
ILSI's Monographs on Pathology of Laboratory Animals: Nonhuman
Primates I, Jones TC, Mohr U, Hunt RD, eds., pp. 5-20, Springer-Verlag,
1993.
- 2. Reimann KA, et al: A chimeric simian/human immunodeficiency
virus expressing a primary patient human immunodeficiency virus
type 1 isolate env causes an AIDS-like disease after in vivo
passage in rhesus monkeys. J Virol 70:6922-6928, 1996.
- 3. Reimann KA, et al.: An env gene derived from a primary
human immunodeficiency virus type 1 isolate confers high in vivo
replicative capacity to a chimeric simian/human immunodeficiency
virus in rhesus monkeys. J Virol 70:3198-206, 1996.
- 4. Lu Y, Pauza CD, Lu X, Montefiori DC, Miller CJ: Rhesus
macaques that become systemically infected with pathogenic SHIV
89.6-PD after intravenous, rectal, or vaginal inoculation and
fail to make an antiviral antibody response rapidly develop AIDS.
J Acquir Immune Defic Syndr Hum Retrovirol 19:6-18, 1998.
-
Case II - Labeled "B" (AFIP 2639067)
- Signalment: Five-month-old, Thoroughbred, male, equine.
-
- History: The weanling presented with a three-day history
of watery diarrhea, dehydration, dependent edema and signs of
endotoxemia. The diarrhea resolved within 24 hours of initiating
therapy (IV fluids, banamine, bacitracin, and pentoxifylline),
but hypoproteinemia persisted. The animal collapsed and was euthanized.
-
- Gross Pathology: There was moderate edema of hind
legs and scrotum. The intestinal contents were grossly unremarkable,
and formed feces were pres-ent within the small colon. The mucosa
of the distal meter of the ileum was thickened and rugose. The
cecum and pelvic flexure of the large colon were markedly edematous.
-
- Laboratory Results: Bacterial cultures were negative
for significant pathogens, including Rhodococcus equi and multiple
cultures for Salmonella spp. and Clostridium spp. Parasitology
was negative for Cryptosporidium, Giardia, and other parasites.
-
- Contributor's Diagnosis and Comments: Ileum: Proliferative
enteropathy - Lawsonia intracellularis-like bacterium.
-
- On histopathologic examination, the ileal mucosa is diffusely
thickened by elongated, branching, hyperplastic crypts lined
by immature enterocytes. Warthin-Starry stained sections reveal
large numbers of small curved bacteria within the apical cytoplasm
of crypt and villar enterocytes. Sections of ileum sent for PCR
analysis using primers for porcine Lawsonia intracellularis were
positive.
-
- Proliferative enteropathy has been reported in several animal
species, including the pig, horse, dog, white-tail-ed deer, blue
fox, guinea pig, ferret, hamster, rat and rabbit. Gross and histological
findings in this case are similar to previously published cases
in foals, thought to be caused by Lawsonia intracellularis, or
a closely related organism.
 10x
obj.
10x
obj.
- Case 22-2. Small intestine. Crypts are tortuous and
crypt epithelium is piled up and contains frequent mitotic figures.
Low numbers of macrophages and lymphocytes expand the lamina
propria.
 Warthin
Starry stain, 40x obj.
Warthin
Starry stain, 40x obj.
- Case 22-2. Small intestine. There are numerous silver-positive
curved bacilli within the apical zone of crypt epithelial cells.
-
- AFIP Diagnosis: Small intestine: Enteritis, proliferative,
subacute, diffuse, severe, with mild diffuse submucosal edema,
and multifocal villar fusion, crypt herniation, and crypt abscesses,
Thoroughbred, equine.
-
- Conference Note: Proliferative enteritis or enteropathy
occurs in a number of animal species. Among domestic animals,
the disease is economically important in swine. In laboratory
animals, the condition is an important cause of enteritis in
hamsters. The etiology of the proliferative enteropathy in swine
remained unknown until recently when it was identified as Lawsonia
intracellularis. An organism nearly indistinguishable from L.
intracellularis has also been isolated from hamsters. Organisms
similar to L. intracellularis have been identified in lesions
of proliferative enteritis/colitis in rabbits, deer, ostriches,
horses, and ferrets; the organisms are closely related to L.
intracellularis.
-
- There is some variation among affected species in the location
of gross lesions. Lesions have been reported in the ileum of
horses, sheep, ostriches, guinea pigs, rabbits, hamsters, and
swine; in the stomach and ileum of dogs; in the cloaca of emus;
and in the colon of foxes, rats, and ferrets. Histologically,
the disease is characterized by crypt hyperplasia and numerous
small, curved, intracellular bacteria in the apical cytoplasm
of infected enterocytes, usually only visible with silver stains
(such as Steiner's or Warthin-Starry methods). Thus, despite
the variability in location of gross lesions, enterocyte proliferation
and intracellular organisms are the two common histologic features
of proliferative enteropathy in animals.
-
- Contributor: Animal Health Laboratory, Laboratory
Services Division, University of Guelph, Box 3612, Guelph, Ontario,
CANADA N1H 6R8.
-
- References:
- 1. Williams NM, Harrison LR, Gebhart CJ: Proliferative enteropathy
in a foal caused by Lawsonia intracellularis-like bacterium.
J Vet Diagn Invest 8:254-256,1996.
- 2. Duhamel GE, Wheeldon EB: Intestinal adenomatosis in a
foal. Vet Pathol 19:447-450, 1982.
- 3. Cooper DM, Gebhart CJ: Comparative aspects of proliferative
enteritis. J Amer Vet Med Assoc 212:1446-1450, 1998.
-
Case III - B98-5016 (AFIP 2639016)
- Signalment: Ten-year-old, captive-born, female, Indochinese
tiger (Panthera tigris corbetti).
-
- History: The animal, housed in a zoo, presented with
mild neurologic signs. Eleven days later, marked ataxia and paraparesis
were observed, with forelimbs more severely affected than hind
limbs. Neurologic signs were unchanged on day sixteen. Physical
examination revealed normal muscle mass and tone, and normal
to hyper-reflexia in all limbs. On day 17, the animal was eating
well but had developed mild head tremors which persisted for
two days. By day 27, the paraparesis had worsened. On day 30,
analysis of cerebrospinal fluid showed a mild pleocytosis, but
was otherwise unremarkable. The animal was euthanatized on day
38.
-
- Gross Pathology: Gross postmortem examination revealed
healing fractures of the dorsal spinous processes of C7, T1,
T3 and T4. No other significant lesions were noted.
-
- Laboratory Results: Hematology, serum chemistries, and urinalysis
were unremarkable. Titers for feline leukemia virus, feline infectious
peritonitis virus, feline immunodeficiency virus and toxoplasmosis
were negative.
-
- Contributor's Diagnosis and Comments: Nonsuppurative
and demyelinating meningomyelitis, cervical spinal cord.
Etiology: Canine distemper virus.
-
- Histopathologic findings were most pronounced in the brain
stem and cervical spinal cord. Alterations included nonsuppurative
meningo-encephalomyelitis, gliosis, and irregular parenchymal
necrosis that was most pronounced in sections of cervical spinal
cord. Descending tracts in the spinal cord white matter exhibited
demyelination and axon swelling. Astrocytes in sections of brain
stem contained eosinophilic intranuclear inclusion bodies that
were confirmed to be canine distemper virus by immunohistochemistry
(courtesy of Dr. Brian Summers, Cornell University). No significant
lesions were noted in other tissues. Just after canine distemper
was diagnosed in this tiger, two wild raccoons showing neurologic
signs were captured on zoo grounds and confirmed to have canine
distemper.
-
- In the past several years, canine distemper virus (CDV) infection
has been reported in several species of exotic cats, including
snow leopards and lions (Fix et al., 1989, Roelke-Parker et al.,
1996). Although many believe that this is a relatively recent
phenomena, a retrospective survey of archived tissues from a
zoo in Switzerland demonstrated positive immunoreactivity to
CDV in 12 of 42 lions and tigers necropsied from 1972 to 1992
(Myers et al., 1997). Some molecular evidence indicates that
outbreaks in felids likely originate from feral non-felid carnivores
(Harder et al., 1996). These events continue to build evidence
for the ability of morbilliviruses to expand their host range,
as is also known for several species of cetaceans and phocids.

- Case 22-3. Spinal cord. Numerous punched out areas
represent necrosis and loss of white matter. Note the macrophages
in the center of the field (Gitter cells). There is a mild perivascular
infiltrate of lymphocytes.

- Case 22-3. Spinal cord. There is diffuse degeneration
and loss of myelin in axonal tracts (spongiosis). A single glial
cell in the center contains an eosinophilic intranuclear inclusion
(arrow).
-
- AFIP Diagnosis: Spinal cord: Demyelination, multifocal,
severe, and moderate nonsuppurative meningomyelitis and few glial
eosinophilic intranuclear inclusions, Indochinese tiger (Panthera
tigris corbetti), feline.
-
- Conference Note: Canine distemper virus (CDV) is a
morbillivirus, as are measles virus, rinderpest virus, peste
des petits ruminants virus and recently recognized phocine and
cetacean viruses. Morbilliviruses, members of the family Paramyxoviridae,
are enveloped, single-stranded, RNA viruses that measure between
150-300 nm in diameter. There is one serotype of CDV, but multiple
strains occur which differ in virulence and neurotropism.
-
- Conference participants favored canine distemper virus infection
based upon the histopathologic findings of nonsuppurative meningomyelitis
with demyelination and intranuclear inclusions. Differential
diagnosis considered by attendees included pseudorabies virus
(Herpesvirus suis) and feline rhinotracheitis virus (feline herpesvirus
type 1).
-
- Contributor: The Procter & Gamble Company, Miami
Valley Laboratories, PO Box 398707, Cincinnati, Ohio 45239-8707.
-
- References:
- 1. Fix AS, et al.: Feline panleukopenia virus and subsequent
canine distemper virus infection in two snow leopards (Panthera
uncia). J Zoo Wildl Med 20:273-281, 1989.
- 2. Harder TC, et al.: Canine distemper virus from disease
large felids: Biological properties and phylogenetic relationships.
J Gen Virol 77:397-405, 1996.
- 3. Myers DL, et al.: Distemper - not a new disease in lions
and tigers. Clin Diagn Lab Immunol 4:180-4, 1997.
- 4. Roelke-Parker ME, et al.: A canine distemper virus epidemic
in Serengeti lions (Pantera leo). Nature 379:441-5, 1996.
- 5. Fenner F, et al.: Paramyxoviridae. In: Veterinary Virology,
Fenner F, et al., eds., pp. 485-501, Academic Press, San Diego,
CA, 1987.
- 6. Summers BA, Cummings JF, de Lahunta A: Inflammatory diseases
of the central nervous system. In: Veterinary Neuropathology,
Summers BA, Cummings JF, de Lahunta A, eds., pp. 103-110, Mosby
Yearbook, Saint Louis, MO, 1995.
- 7. Dungworth DL: The respiratory system. In: Pathology of
Domestic Animals, Jubb KVF, Kennedy PC, Palmer N, eds., 4th edition,
vol. 2, pp. 558, Academic Press, San Diego, CA, 1993.
- 8. Jones TC, RD Hunt, NW King: Diseases caused by viruses.
In: Veterinary Pathology, 6th edition, pp. 233-234, Williams
and Wilkins, Baltimore, MD, 1997.
Case IV - 98A-25996 (AFIP 2641596)
- Signalment: Five-month-old, Angus heifer, bovine.
-
- History: This heifer had been pastured alone and was
found dead without prior signs of illness.
-
- Gross Pathology: The carcass was well-fleshed. The
tissues were icteric and pale. The urine was red and clear. The
spleen was mildly enlarged, and the liver was diffusely pale
tan.
-
- Laboratory Results: Fluorescent immunostains on frozen
sections of kidney and liver were positive for Leptospira sp.
-
- Contributor's Diagnoses and Comments:
- 1. Liver: Erythrophagocytosis, canalicular bile plugs, multifocal
acute hepatocellular necrosis and intralesional leptospiral bacteria.
- 2. Kidney: Mild acute purulent tubular nephritis with intralesional
leptospiral bacteria.
-
- Animals infected by Leptospira sp. have an initial bacteremia
followed by localization in the kidney, where organisms multiply
in proximal convoluted tubule lumens and are excreted in urine.
Clinicopathological manifestations of bovine leptospirosis include
hemolytic anemia, hemoglobinuria, icterus, abortion, mastitis,
and nephritis. Many serovars may be responsible for disease,
including Leptospira hardjo (for which cattle are reservoir hosts),
L. pomona, L. icterohemorrhagiae, L. canicola, L. grippotyphosa,
L. szwajizak, L. balcanica. The specific serovar responsible
for illness in the present case was not determined.
- Acute leptospirosis is most severe in calves and usually
manifests as hemolytic anemia. The gross lesions noted in this
case are typical of the acute septicemic form of disease. Histologic
lesions are often mild and non-specific. In the kidney, there
is edema, degeneration and necrosis of tubular epithelial cells,
and intratubular neutrophilic exudate. After a day or two, hemoglobin
pigment may accumulate within tubules. In the liver, there may
be disaggregation of hepatic cords and necrosis of individual
hepatocytes, or a more zonal pattern attributable to hypoxia.
In subacute (or post-subclinical) phases, the organisms localize
in kidneys and cause interstitial nephritis.

- Case 22-4. Kidney. There is tubular degeneration and
necrosis (vacuolation, karyorrhexis), multifocal neutrophilic
infiltrates in tubular lumens, and mononuclear cells within the
interstitium.

- Case 22-4. Liver. There is periportal infiltration
by lymphocytes, and focal degeneration and necrosis of hepatocytes.
Several Kupffer cells contain erythrocytes (erythrophagocytosis).
-
- AFIP Diagnoses:
- 1. Kidney: Nephritis, tubulo-interstitial, neutrophilic and
lymphoplasmacytic, multifocal, mild, with erythrophagocytosis,
Angus, bovine.
2. Liver: Hepatitis, portal, lymphoplasmacytic, diffuse, mild,
with multifocal and centrilobular hepatocellular degeneration
and necrosis, and erythrophagocytosis.
-
- Conference Note: Rare argyrophilic spirochetal bacteria
were identified within hepatic sinusoids and renal tubules by
Steiner's method. Conference participants did not observe evidence
of bile stasis in the examined sections.
- Leptospira sp. bacteria are commonly referred to as spirochetes.
The organisms are slender, helically-coiled, single-celled, aerobic,
and motile by means of periplasmic flagellae. The bacteria are
not visible in standard hematoxylin and eosin stained tissue
sections, but may be seen by darkfield microscopy, electron microscopy,
tissue silver stains, fluorescent antibody methods, and immunohistochemical
stains.
-
- Leptospirosis is a zoonotic disease found worldwide, and
infection is caused by antigenically distinct serovars of the
species Leptospira interrogans. The bacteria are maintained in
the environment by infected domestic animal and wildlife reservoir
hosts. Transmission may occur by direct contact with infected
urine, venereal or placental transfer, bite wounds, or ingestion
of infected tissues. Indirect transmission can occur under favorable
environmental conditions, such as contact with contaminated stagnant
or slow-moving water.
-
- The liver and kidney are the two primary parenchymatous organs
affected by leptospiral bacteremia. In dogs, icterus is attributed
to hepatic dysfunction induced by leptospiral toxins, which cause
hepatocellular degeneration and necrosis. In severely affected
calves, acute leptospiremia causes hemolytic anemia, hemoglobinuria,
jaundice, pulmonary congestion, and occasionally meningitis.
Icterus in calves occurs as a result of hemolysis due to hemolysin
from the bacteria, and from hepatocellular injury of both ischemic
and toxin origin. Hemolytic anemia is initially attributed to
bacterial hemolysins, but may later be due to antibodies reacting
with bacterial products coating red blood cells.
-
- Contributor: Pathology Department, University of Georgia,
College of Veterinary Medicine, University of Georgia, Athens,
Georgia 30602-7388.
-
- References:
- 1. Jones TC, RD Hunt, NW King: Diseases caused by bacteria.
In: Veterinary Pathology, 6th edition, pp. 467-472, Williams
and Wilkins, Baltimore, MD, 1997.
- 2. Miller DA, Wilson MA, Beran GW: Relationships between
prevalence of Leptospira interrogans in cattle, and regional,
climatic and seasonal factors. Amer J Vet Res 52:1766-1768, 1991.
- 3. Greene CE, Miller MA, Brown CA: Leptospirosis. In: Infectious
Diseases of the Dog and Cat, Greene CE, ed., 2nd ed., pp. 273-282,
WB Saunders, Philadelphia, PA, 1998.
- 4. Maxie MG: The kidney. In: Pathology of Domestic Animals,
Jubb KVF, Kennedy PC, Palmer N, eds., 4th edition, vol. 2, pp.
503-511, Academic Press, San Diego, CA, 1993.
-
- Conference Coordinator:
- Ed Stevens, DVM
Captain, United States Army
Registry of Veterinary Pathology*
Department of Veterinary Pathology
Armed Forces Institute of Pathology
(202)782-2615; DSN: 662-2615
Internet: STEVENSE@afip.osd.mil
-
- * The American Veterinary Medical Association and the American
College of Veterinary Pathologists are co-sponsors of the Registry
of Veterinary Pathology. The C.L. Davis Foundation also provides
substantial support for the Registry
- Return to WSC Case Menu
 4x
obj.
4x
obj.
 40x
obj.
40x
obj.
40x
obj.
40x
obj.
 20x
obj
20x
obj 40x
obj
40x
obj
 10x
obj.
10x
obj.
 Warthin
Starry stain, 40x obj.
Warthin
Starry stain, 40x obj.



